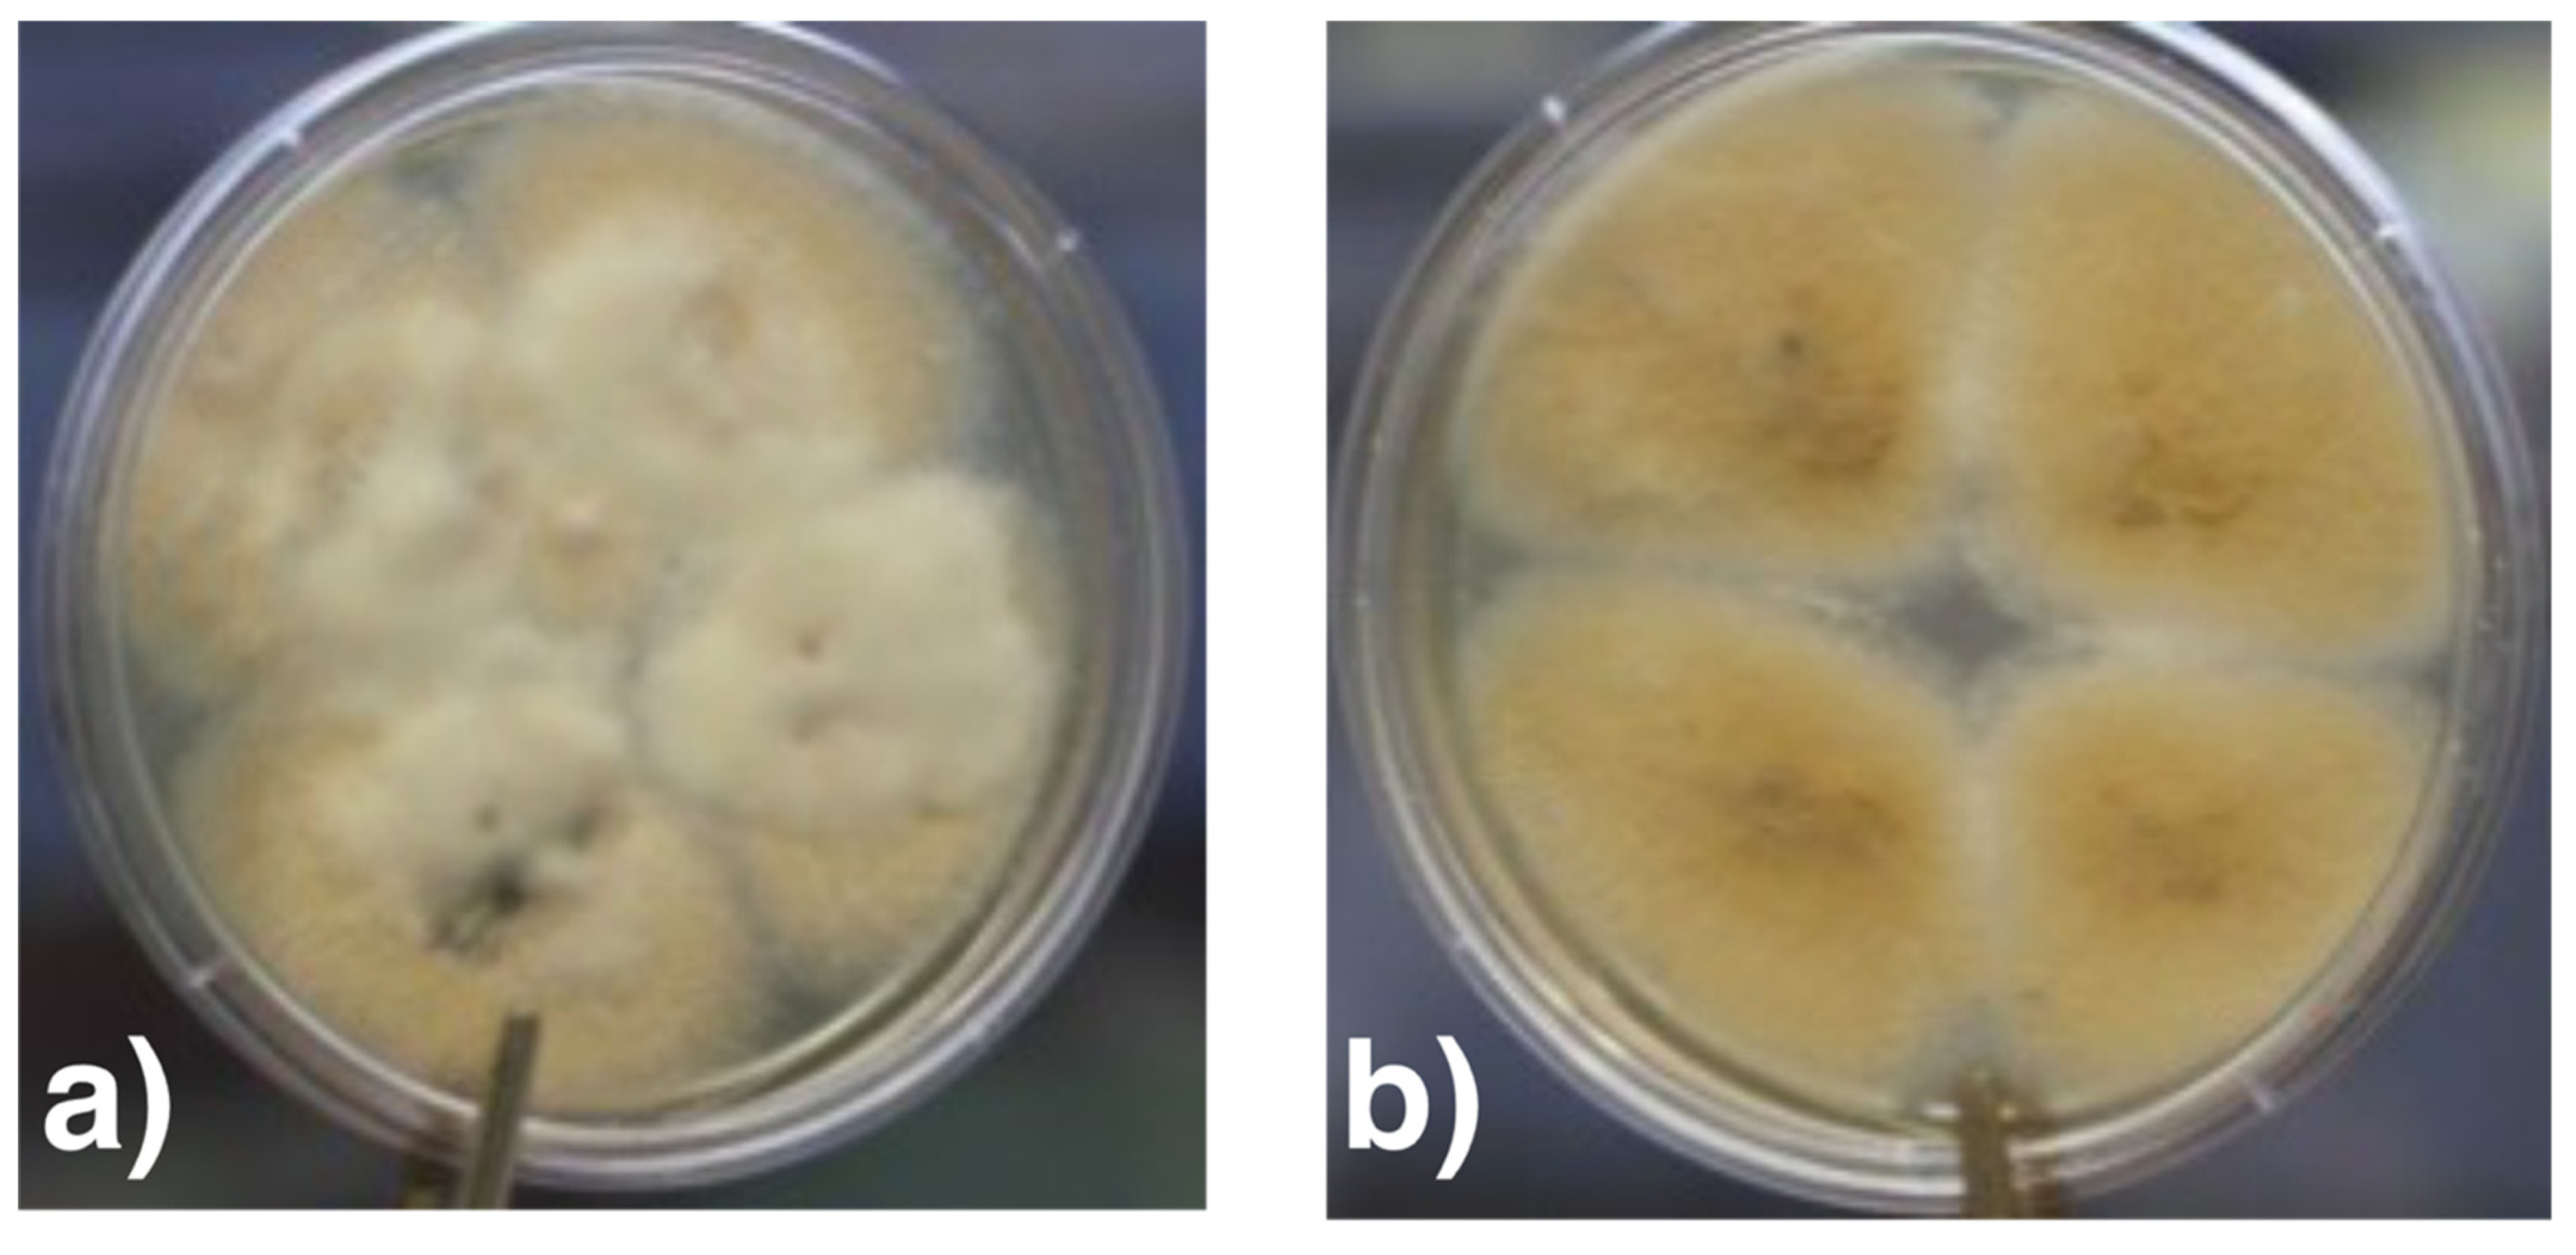
Jof 07 01093 g009

Abstract
Fusarium spp. are moulds ubiquitously distributed in nature and only occasionally pathogenic for humans. Species of the Fusarium solani complex are the predominant keratitis-inducing pathogens, because they are endowed with proper virulence factors. These fungi can adhere to the cornea creating a biofilm and, with the help of enzymes and cytotoxins, penetrate the cornea. Whereas an intact cornea is hardly able to be invaded by Fusarium spp. in spite of appropriate virulence factors, these opportunistic fungi may profit from predisposing conditions, for example mechanical injuries. This can lead to a progressive course of corneal infection and may finally affect the whole eye up to the need for enucleation. Here, we present and discuss the clinical, microbiological and histopathological aspects of a particular case due to Fusarium tonkinense of the Fusarium solani complex with severe consequences in a patient without any obvious predisposing factors. A broad portfolio of antifungal agents was applied, both topically and systemically as well as two penetrating keratoplasties were performed. The exact determination of the etiologic agent of the fungal infection proved likewise to be very challenging.
1. Introduction
Fusarium spp. are a heterogenous group of ascomycetous moulds. With about 300 recognized phylogenetic species, Fusarium is one of the largest genera of fungi. Its complex phylogeny comprises 29 lineages including 20 species complexes and 9 single species [1]. The taxonomic delimitation of the genus is currently a matter of debate: a small generic concept that splits Fusarium in several genera (e.g., Neocosmospora) [2,3] and a wide generic concept that keeps Fusarium with all species complexes including the Fusarium solani species complex (syn. Neocosmospora) [4,5]. We use the latter concept, because the morphological recognition of Fusarium spp. is of great importance in diagnostics.
In nature, Fusarium spp. are present on plants, in the soil, air as well as water [6]. The majority of species, such as F. verticillioides and F. graminearum, are typically plant pathogens and therefore contribute to some of the greatest problems facing humanity, namely hunger and malnutrition. A common characteristic of Fusarium spp. is their pronounced capability to produce a wide range of mycotoxins, e.g., trichothecenes, including nivalenol, deoxynivalenol (also known as vomitoxin), fumonisin and zearalenone, all of which are ingested with food, and the consequences of which are largely underestimated by the human medical field [7].
From a medical perspective, Fusarium spp. are rather harmless environmental microbes that rarely cause human infections [6]. Opportunistic species are occasionally found as pathogens in patients with impaired immune systems, e.g., patients with leukemia, and can lead to a disseminated infection affecting practically all organs [7].
In addition, Fusarium spp. are a leading cause of fungal eye infections which have shown an increasing incidence in recent years [6,8]. Even keratitis outbreaks have been reported associated with the use of a certain brand of lens solutions [9,10]. In contrast to bacterial forms of keratitis, the course of Fusarium keratitis is usually more progressive [6,8] and the consequences generally more serious [8,11,12], not least because the antifungal therapy is less efficient, since these fungi are a priori resistant to many types of antimycotics [8,11,13]. There is evidence that these pathogens possess certain virulence factors that enable destruction of tissue barriers and progression [6,14]. Fungi from the F. solani species complex such as F. falciforme, F. keratoplasticum, F. petroliphilum are particularly common in cases of Fusarium keratitis besides F. oxysporum, F. proliferatum (out of the F. fukikuroi complex) and others [6,8,11].
We present a case in which the patient developed an infectious keratitis due to F. tonkinense (syn. Cylindrocarpon tonkinense, Neocosmospora tonkinensis) of the F. solani species complex. Despite intensive conservative and subsequently surgical therapy, the clinical course deteriorated rapidly with spreading of the infection into the anterior chamber and finally into the vitreous body.
2. Case Report
2.1. Clinical Presentation
A 58-year-old woman presented at the hospital with a corneal infiltrate that had been refractory to the outpatient treatment. According to the referring doctor, it had started with an edematous lesion approximately one week ago and was initially treated with topical antibiotics (ofloxacin) and steroids (dexamethasone). Acyclovir ointment was added because of the development of a presumed herpes-like ulcer, but without satisfying results. At the time when the patient was admitted to hospital, the cornea showed a white, gelatinous paracentral corneal infiltrate measuring approximately 3.0 × 1.5 mm and a discrete peripheral infiltration measuring about 0.5 mm (Figure 1). The infiltrate was surrounded by an epithelial edema and the endothelium had some dense whitish plaques. The conjunctiva showed a circularly moderate injection. The subsequent inflammation in the anterior chamber manifested itself with aqueous flare of 2+ and inflammatory cells of 1+. Fundus and vitreous body showed no ophthalmoscopic or sonographic evidence of inflammation.
Figure 1.
Biomicroscopic slit-lamp photography of the left eye upon inpatient admission. Clinical findings demonstrated a white, gelatinous paracentral corneal infiltrate (3.0 × 1.5 mm) and discrete peripheral infiltration (0.5 mm) at 10 o’clock.
The patient’s history did not reveal any evidence of a (micro)traumatic incident, contact lens use, or an ocular disease in the past. Systemically, the patient suffered from drug-treated arterial hypertension. There were no indications for a diabetic disease. Four years ago, the patient had undergone radiotherapy and chemotherapy because of a carcinoma of the lower jaw, in addition to a surgical tumour resection (up to now without recurrence). Additionally, she suffered from a (progressive) depressive disorder requiring medically supervised drug therapy.
Due to the initial clinical suspicion of a fungal infection at hospital admission, diagnostic corneal abrasions in the affected area were repeatedly performed. However, the microbiological findings did not show evidence of microorganisms (HSV-, VZV-PCR, bacterial growth, microscopic examination for acanthamoeba or fungi, respectively). Despite adjusting and intensifying topical therapy, using azithromycin and ganciclovir, and subsequently voriconazole (2%), the infiltrate began to spread extensively to all corneal layers and a white gossamer structure, attached to the posterior cornea, developed. Given the foudroyant progression (Figure 2) (and the continued lack of evidence of specific pathogens), a therapeutic penetrating keratoplasty (graft diameter of 8.0 mm) was performed with complete macroscopic removal of the lesion (8 weeks after the onset of the disease). During the first postoperative days, we observed an anterior segment almost without irritation and a clear graft and host cornea.
Figure 2.
Biomicroscopic slit-lamp photography of the left eye before the first keratoplasty with significant expanded infiltration penetrating all corneal layers and intrusion in the anterior chamber.
In the excised host cornea, Fusarium spp. was identified by culture for the first time. However, the isolate showed high MICs for most antifungals except of natamycin (Table 1).
Table 1.
Antifungal susceptibility testing results for F. tonkinense NRZ-2021-193.
Due to the development of a new corneal infiltrate starting from the remaining host cornea (Figure 3) rapidly spreading to the graft (Figure 4), the treatment was extended with topical natamycin and polyhexamethylene biguanide (at times applied hourly), systemic voriconazole (200 mg 2× daily) and terbinafine (250 mg 1× daily), as well as continuous intracameral and intravitreal injections of voriconazole (100 µg/0.1 mL) and amphotericin B (7.5 µg/0.1 mL) at intervals of several days. Voriconazole was also administered intrastromally in the peripheral cornea. Repeated microbiological examinations of samples collected from the anterior chamber and vitreous body provided no new findings.
Figure 3.
Biomicroscopic slit-lamp photography of the left eye one week after first keratoplasty with again incipient infiltration spreading from the remaining host cornea.
Figure 4.
Biomicroscopic slit-lamp photography of the left eye 3 weeks after the first keratoplasty with extended circular infiltration of the host and graft cornea. The epithelial defect is due to repeated corneal abrasion to improve drug penetration.
Despite a short period of clinical improvement during the above-mentioned treatment, the overall course of the disease was further progressive and a large-diameter repeat keratoplasty (graft diameter of 13.0 mm, 32 interrupted sutures) was performed 1 month after the first keratoplasty.
The histologic examination of the corneal explant (graft with adjacent host tissue) demonstrated that the focus of inflammation with fungal hyphae was mainly located in the posterior corneal stroma of the host cornea near the interface area. The corneal graft showed an acute ulcerative keratitis close to the graft margin. Following once again an only minimal-irritative anterior segment status and clear corneal transplant within the first postoperative days, white, viscous material sprawling from the iridocorneal angle (Figure 5) appeared and the corneal transplant and the anterior chamber developed a progressive diffuse infiltration.
Figure 5.
Biomicroscopic slit-lamp photography of the left eye one week after a large-diameter (13.0 mm) repeat keratoplasty with again white-viscous material in the inferior iridocorneal angle.
Over the next weeks and months with continued intensive topic and systemic therapy as well as intracameral and intravitreal injections, the course of the disease stagnated indeed temporarily, but the overall status continued to deteriorate and, finally, the vitreous body became affected, too (Figure 6a,b).
Figure 6.
Biomicroscopic slit-lamp photography (a) and B-scan (b) of the left eye before enucleation with continuing progression in the anterior segment and beginning endophthalmitis.
With the continuing progression of the endophthalmitis (and at the patient’s urging) after several months of treatment with considerable mental and physical strain, we eventually decided to proceed with the ultima ratio of enucleation. This intervention and the subsequent course passed without further complications. Within a short period of time the conjunctiva of the eye socket was completely irritation-free and the patient could be fitted with a cosmetically pleasing prosthesis.
2.2. Histology
After the removal of specimen for microbiologic examinations (s. above), the enucleated eye was preserved at −70 °C and then immediately after thawed in 8% formalin solution.
The histologic examination revealed a necrotizing inflammatory reaction consisting of neutrophil granulocytes mainly in the cornea and adjacent chamber angle, iris and anterior chamber (Figure 7a,b) but could not detect (neither with the Grocott Gomori stain nor with the PAS stain) fungal elements within the whole eye.
Figure 7.
Histopathological examination of the anterior segment. (a) Necrotizing inflammatory reaction consisting of neutrophil granulocytes mainly in the cornea (***) and adjacent chamber angle (**), iris (*) and anterior chamber (°). Periodic acid Schiff stain, bar = 500 µm. (b) Enlarged area inside the square of figure a containing necrotic neutrophil granulocytes between the corneal stroma lamellae (Periodic acid Schiff stain, bar = 50 µm).
The vitreous contained sparse neutrophil granulocytes, few unspecific lymphocytic infiltrates were found in the choroidea. There were lytic changes of the otherwise normal appearing retina, which rather represented a freeze-thawing artifact. The artificial detachment of the retina was due to pre-freezing manipulation to obtain microbiological samples (Figure 8).
Figure 8.
Artificially detached normal appearing retina with lytic changes, which rather represent a freeze-thawing artifact. The artificial detachment is due to pre-freezing manipulation to obtain microbiological samples (Periodic acid Schiff stain, bar = 250 µm).
2.3. Microbiology
No bacteria were identified using eubacterial PCR testing in the intraoperatively collected corneal sample during the first therapeutic keratoplasty. However, the panfungal PCR results were positive. Blood agar, chocolate blood agar, and Sabouraud agar were inoculated. After 3 days of incubation at 26 °C, a mould was isolated. No bacterial growth was identified on blood, chocolate or McConkey agar.
Based on the colony morphology on Sabouraud agar (Figure 9a,b) and the micromorphological characteristics (Figure 10a,b), the fungus was classified as Fusarium spp.
Figure 9.
Colony morphology of isolated Fusarium sp. after 10 days on Sabouraud agar at 26 °C. (a) Front side: Fluffy colony (b) Reverse side: ochre-coloured pigment.
Figure 10.
Micromorphology of Fusarium tonkinense (differential interference contrast microscopy). (a) Mycelial strand with conidiohores. (b) Curved microconidia. Scale bars = 20 µm.
Molecular identification via amplification/sequencing of the ITS (internal transcribed spacer) region and the translation elongation factor 1α (TEF) were performed as described previously [8]. The ITS and TEF sequences unambiguously identified the strain as F. tonkinense: the ITS sequence (GenBank accession number MZ707714) was 100% identical with that of the ex-type strain of F. tonkinense CBS 115.40 (GenBank accession number: NR_170733). No TEF sequence of the ex-type strain of F. tonkinense is available but the TEF sequence of NRZ-2021-193 (GenBank accession number: MZ703012) shows 100% similarity with strain IFM:JPN:62225 (GenBank accession number: LC177294) which is a reference strain of the phylogenetic species 9 of the Fusarium solani species complex (FSSC 9) that is now named F. tonkinense [15]. The strain is deposited in the Jena Microbial Resource Collection (JMRC): NRZ-2021-193.
Antifungal susceptibility testing was performed by microdilution using the EUCAST protocol [16]. The isolate showed high MICs for most antifungals except for natamycin which is considered to be effective up to MICs of 16 mg/L, as this concentration can be reached at the surface of the eye (Table 1) [17].
The determination of mycotoxin production was carried out in the culture supernatant of the strain in sabouraud broth for 16 days at 26 °C (analogue to the temperature of the eye surface) using ELISA (Immunolab RAPID ELISA: Fumonosin; R-Biopharm-RIDASCREEN: deoxynivalenol, zearalenone, T-2 Toxin). The patient’s strain clearly produced none of the tested mycotoxins in detectable quantities (Table 2).
Table 2.
Mycotoxin production (DL: Detection limit).
Cultures from samples of the anterior chamber fluid and vitreous body from the enucleated eye were negative (neither bacteria nor fungi could be cultivated). The panfungal PCR also showed no signal.
3. Discussion
Fusarium keratitis is relatively common in tropical regions such as South India, and Fusarium spp. are among the leading causes of visual impairment and blindness [18]. In South India, infections are usually found in rural settings, so that it is quite common that agricultural workers in India often become infected after a corneal injury caused by plant or soil material [19]. Fungal keratomycosis in Germany is caused by several agents and among them Fusarium spp. as described in the German keratitis registry [20].
Species of the Fusarium solani species complex are the prevailing agents of Fusarium keratitis [8,21,22]. In Germany, the most common species isolated from keratomycoses are F. petroliphilum, F. keratoplasticum and F. solani [8].
Fusarium tonkinense was originally described as Cylindrocarpon tonkinense in 1939 [23]. In phylogenetic studies, the species was designated as phylogenetic species 9 of the Fusarium solani species complex. When it was recognized that sequences of the ex-type strain of Cylindrocarpon tonkinense fit in this clade, it was renamed Neocosmospora tonkinensis [2] and later transferred to Fusarium tonkinense [5]. Using these different names, this species has been reported to cause keratitis in several countries including Colombia [24], Germany [8,11], Japan [15], UK [25] and USA [26].
The predisposing factors are numerous but often remain unclear in individual cases. The principal risk factors are the use of contact lenses and trauma or operative intervention, damage to the cornea, or blocked tear ducts [14]. In Germany, the majority of affected patients are otherwise healthy women of approximately 50 years of age [11]. Indeed, none of the common predisposing factors were identified in the case presented here.
The infection generally does not remain limited to only the cornea but rather breaks through the anatomical barrier, namely Descemet’s membrane, which allows the pathogen to penetrate into the eye causing endophthalmitis. With the help of mannoproteins on their surface, Fusarium spp. are able to adhere to laminins, fibronectins and collagens on the cornea and propagate at the given temperature [14]. Furthermore, Fusarium spp. are able to use their genetic repertoire to create a biofilm covering the cornea. This protects them against numerous non-specific immune mechanisms and against topical antifungals [6]. Once they produce large amounts of proteases, phospholipase, and cytotoxic peptides [27], they can destroy the antimicrobial oligopeptides of the non-specific defences (such as lysozyme and defensins) and trigger the development of corneal ulceration causing penetration and enabling the invasion of the anterior chamber [6,14].
As soon as this hurdle has been overcome, severe inflammatory reactions are triggered because the pathogen-associated microbial patterns (PAMPs) of the fungi, such as glucan (large amounts of which are contained in the cell walls), activate the pattern recognition receptors (PRRs) of the host cells, especially dectin 1 and CD36. This increases the levels of proinflammatory cytokines IL-1, IL-6, IL-8, IL-17, IL-23 and IFN-γ in the aqueous humour significantly [14].
In such an eye with an intensive inflammatory reaction, anatomical alterations may develop which in turn restricts the outflow of aqueous humour, causing increased intraocular pressure and possibly leading to therapy-resistant glaucoma [6]. In the isolate NRZ-2021-193 particular virulence factors are not assessed. Whereas in principle, destructive, cytotoxic and immunotoxic mycotoxins, especially trichothecenes [7] acting as virulence factors [28] or as pathogenicity factors [29], might support the pathogenetic development of the fusarioses [6], mycotoxin production could, however, not be detected in the strain NRZ -2021-193 (Table 2), at least under the given, i.e., rather growth promoting, in vitro nutritive conditions [7]. This does not exclude entirely that under the local conditions on the eye and the hostile environment due the presence of defence mechanisms, such as lysozyme, mycotoxin production may have occurred anyway and possibly supported the progression. Another particular characteristic of Fusarium spp. is the development of adventitious spores within an infected tissue [30]. This phenomenon has also been described in a Fusarium strain isolated from keratitis [31]. The pathogenic role of this trait in keratitis remains obscure until now, but it could be responsible for clinical failure of antimycotic therapy and for persistence.
Manifestation in the deep corneal stroma is typical for Fusarium spp., which is why identification of the pathogen by corneal swabs or scrapings is often negative [32]. Especially for deep stromal manifestation, in vivo confocal microscopy can contribute to initiate a rapid empirical therapy by identifying the fungal elements (shown as hyperreflective parallel lines). In the later course, therapy can be adjusted according to closer pathogen identification. This therapeutic modality has a high sensitivity and may prevent disease progression with serious outcome as a supplement to other diagnostics (microscopic examination, culture, polymerase chain reaction) [33,34].
Fatal progression—even after large-diameter keratoplasty [35]—is partly explained by the fact that such an infection is difficult to treat with drugs, since Fusarium spp. are inherently resistant to many antifungals [11,13,36,37,38] and even to the polyene amphotericin B disposing MIC90 levels of >1 mg/L [13]. According to a study by Lalitha et al., natamycin could be considered as effective as voriconazole for Fusarium species, provided corneal penetration is not an issue [17]. Indeed, the concentration in the 5% solution is far beyond the MIC, namely 50.000 mg/L. In antifungal susceptibility testing based on the EUCAST protocol, all tested species, except for some strains of F. solani, showed natamycin MIC ≤ 8 mg/L [8] while in tests performed according to the CLSI protocol only 65% of the species showed natamycin MICs ≤ 16 mg/L [18]. One explanation for the relatively good activity could be a particular mechanism of action of natamycin against Fusarium spp. [39,40]. A prolonged topical therapy using natamycin (5%) is reported as an option to prevent progression or recurrence [41], using increased concentrations hourly or in even shorter treatment intervals and trying to achieve an effective local concentration through topical application. Since the half-life of topically administered drugs is only about 4 min [42], it is recommended that the eye lids should remain closed for about two minutes, so that definitely higher amounts of the agents will persist in the tear film than compared to active movements of the lids [43]. In addition, the naso-lacrimal ducts should be compressed mechanically with the patient’s fingers so that the drug cannot evade through this pathway [44]. High-frequency application is also important. However, natamycin has a high molecular weight and is therefore unable to penetrate the corneal epithelium or even into deeper compartments of the eye [13,32]. Thus, in order to increase the probability of therapeutic success by promoting the access of the drug into the infected eye compartment, an abrasion of the epithelium is recommended. In the future, luliconazole, an imidazole derivative, might provide a highly effective treatment method against Fusarium spp. [45]. This may also be held true for fosmanopegix, a first-in-class prodrug of manogepix. This drug active against Fusarium spp. interfering specifically with the synthesis of a fungal protein of the cell wall, namely mannoprotein representing an essential constituent, is in the pipeline for ophthalmologic use. It is well tolerated after oral as well as intravenous application because of the selective mechanism of action [46].
Intrastromal administration of voriconazole might be an effective way of providing higher concentrations of the drug especially when there is a risk of conreal mel and perforation. Indeed, intrastromal injection of (0.05–0.1 mL) aided the resolution of various fungal infections [47].
For intraocular infections, voriconazole [48] and/or amphotericin B intraocular injection may be required in an attempt to achieve a concentration above the MIC with the aim of combatting the otherwise resistant pathogens (Table 1) [32].
Voriconazole is actually the most important antifungal, which in addition to locally applied drugs, can be given intravenously. This therapy should be taken into consideration irrespective of the in vitro susceptibility, since good clinical response in hematologic patients could be observed even when administered in cases with resistant pathogens and vice versa [49]. Another option could be terbinafine, although the final clinical value of this drug in clinical cases of fungal keratitis caused by the Fusarium spp. remains still to be elucidated. Whereas this antimycotic showed good in vitro activity at least against some Fusarium spp. [13,32,50], high MIC values are reported, too [19]. Indeed, the tested strain of F. solani displayed high MIC values (Table 1).
An in-vitro determination of an antimycogram of Fusarium spp. isolated from the cornea is not routinely done and indeed not really necessary and the predictive value for outcome is not stringent. First, because the interpretation of the results is difficult and even arbitrary, since standardized, authoritative breakpoints are not yet available. Second, because for topically applied antimicrobials in general this classification in “susceptible” or “resistant” is dispensable, since the concentrations in eye drops can definitely exceed the measured MIC values.
Despite clinical progression, histology did not reveal any fungi, neither in GMS- nor in PAS-staining, indicating microbiological therapeutical success. Nevertheless, acute necrotizing inflammation was present at the time of enucleation which could be an overreaction of immune response, even after Fusarium as the initial cause was eliminated as described in the literature [12] raising the question of additional anti-inflammatory treatment at this stage of the disease. Repeated antifungal applications did not cause any retinal damage, which was reported especially for the pore-forming amphotericin B. This substance also binds to cholesterol in human cells, but with a 1000-fold lower affinity than to ergosterol in fungal cells. Combinations with terbinafine, which demonstrated good in-vitro activity against plant pathogenic Fusarium, have been mentioned sporadically in fungal keratitis [34,51] when administered orally and topically, although there is not yet sufficient evidence for their clinical efficacy.
4. Conclusions
The case illustrates the often extremely difficult treatment of ocular fungal infections. Despite the broad spectrum of available antifungal agents, even their highly intensive and combined application does not lead to satisfying treatment results in some cases. The risk of drug-induced tissue damage should not be underestimated, especially in case of high-dose and long-term use. It is known that Fusarium spp. are resistant to many of the available antifungal agents. The F. tonkinese strain detected only showed a response to natamycin with an effective concentration achievable in the eye. In clinical use, however, natamycin, as well as voriconazole, terbinafine, amphotericin B or polyhexanide (often effective substances in other cases) remained without significant success. Affection of the vitreous body was presumably prevented for a long time by the preserved iris-lens diaphragm and frequent intravitreal drug administration. Drug-induced retinal damages were not found in the histological examination. For refractory infectious keratitis, surgical intervention should be performed as early as possible to prevent anterior chamber involvement. Retrospectively, a large diameter with single interrupted sutures should have been chosen for the first keratoplasty. In general, topical steroids should be avoided before and immediately (at least for 10 days) after corneal transplantation. In case of recurrence of anterior chamber inflammation, frequent irrigations with drug administration (voriconazole 2% and amphotericin B 0.15%) should be performed. However, in the beginning, no etiologic agent had been identified, especially no fungi, and a keratoplasty including the limbal area involves the potential of severe complications. An astonishing fact is that fungi were not detectable in the enucleated eye (neither histologically nor microbiologically). Obviously, the aggressive therapy finally led to an elimination, but it did not stop the persistence of the inflammatory response. In this context, the (time-delayed) use of steroids should have been be considered earlier.
Although the outcome in this case was unfortunately frustrating, a rapid diagnosis and a prompt therapy initiation (preferably based on a resistogram) are crucial, especially in the case of mycotic infections. New active agents, which are currently undergoing clinical trials, also offer the prospect of further optimized therapeutic approaches in the future.
Author Contributions
Conceptualization, J.S. and H.H.; methodology, C.A.-H., S.S., S.K., S.R.-A., H.H.; writing—original draft preparation, J.S., T.B., H.H.; writing—review and editing, J.S., B.S., T.B., W.B.-B., C.A.-H., H.H.; visualization, T.B.; supervision, J.S., B.S., L.D., H.H.; All authors have read and agreed to the published version of the manuscript.
Funding
This research received no external funding.
Institutional Review Board Statement
Ethical review and approval were waived for this case report, since all samples taken were used for the diagnostic/medical procedures.
Informed Consent Statement
Not applicable.
Data Availability Statement
The data presented in this study are available on request from the corresponding author.
Acknowledgments
We thank O. Kurzai and G. Walther (National Reference Center for Invasive Fungal Infections (NRZMyk), Leibniz Institute for Natural Product Research and Infection Biology—Hans Knöll Institute, Adolf-Reichwein-Str. 23, D-07745 Jena, Germany) for their help for the final characterization of the isolate and their proposals for the discussion of the results.
Conflicts of Interest
The authors declare no conflict of interest.
References
- O’Donnell, K.; Ward, T.J.; Robert, V.A.R.G.; Crous, P.W.; Geiser, D.M.; Kang, S. DNA sequence-based identification of Fusarium: Current status and future directions. Phytoparasitica 2015, 43, 583–595. [Google Scholar] [CrossRef]
- Sandoval-Denis, M.; Crous, P.W. Removing chaos from confusion: Assigning names to common human and animal pathogens in neocosmospora. Pers. Mol. Phylogeny Evol. Fungi 2018, 41, 109–129. [Google Scholar] [CrossRef]
- Sandoval-Denis, M.; Lombard, L.; Crous, P.W. Back to the roots: A reappraisal of Neocosmospora. Pers. Mol. Phylogeny Evol. Fungi 2019, 43, 90–185. [Google Scholar] [CrossRef] [PubMed]
- O’Donnell, K.; Al-Hatmi, A.M.S.; Aoki, T.; Brankovics, B.; Cano-Lira, J.F.; Coleman, J.J.; de Hoog, G.S.; Di Pietro, A.; Frandsen, R.J.N.; Geiser, D.M.; et al. No to Neocosmospora: Phylogenomic and practical reasons for continued inclusion of the Fusarium solani species complex in the genus Fusarium. mSphere 2020, 5, e00810-20. [Google Scholar] [CrossRef] [PubMed]
- Geiser, D.M.; Al-Hatmi, A.; Aoki, T.; Arie, T.; Balmas, V.; Barnes, I.; Bergstrom, G.C.; Bhattacharyya, M.K.K.; Blomquist, C.L.; Bowden, R.; et al. Phylogenomic analysis of a 55.1 kb 19-gene dataset resolves a monophyletic Fusarium that includes the Fusarium solani Species Complex. Phytopathology 2021, 111, 1064–1079. [Google Scholar] [CrossRef] [PubMed]
- Sáenz, V.; Alvarez-Moreno, C.; Pape, P.L.; Restrepo, S.; Guarro, J.; Ramírez, A.M.C. A one health perspective to recognize Fusarium as important in clinical practice. J. Fungi 2020, 6, 235. [Google Scholar] [CrossRef]
- Hof, H. The medical relevance of Fusarium spp. J. Fungi 2020, 6, 117. [Google Scholar] [CrossRef]
- Walther, G.; Zimmermann, A.; Theuersbacher, J.; Kaerger, K.; von Lilienfeld-Toal, M.; Roth, M.; Kampik, D.; Geerling, G.; Kurzai, O. Eye infections caused by filamentous fungi: Spectrum and antifungal susceptibility of the prevailing agents in Germany. J. Fungi 2021, 7, 511. [Google Scholar] [CrossRef] [PubMed]
- Chang, D.C.; Grant, G.B.; O’Donnell, K.; Wannemuehler, K.A.; Noble-Wang, J.; Rao, C.Y.; Jacobson, L.M.; Crowell, C.S.; Sneed, R.S.; Lewis, F.M.T.; et al. Multistate outbreak of Fusarium keratitis associated with use of a contact lens solution. JAMA 2006, 296, 953–963. [Google Scholar] [CrossRef]
- Khor, W.B.; Aung, T.; Saw, S.M.; Wong, T.Y.; Tambyah, P.A.; Tan, A.L.; Beuerman, R.; Lim, L.; Chan, W.K.; Heng, W.J.; et al. An outbreak of Fusarium keratitis associated with contact lens wear in Singapore. J. Am. Med. Assoc. 2006, 295, 2867–2873. [Google Scholar] [CrossRef]
- Walther, G.; Stasch, S.; Kaerger, K.; Hamprecht, A.; Roth, M.; Cornely, O.A.; Geerling, G.; Mackenzie, C.R.; Kurzai, O.; Von Lilienfeld-Toal, M. Fusarium keratitis in Germany. J. Clin. Microbiol. 2017, 55, 2983–2995. [Google Scholar] [CrossRef]
- Lübke, J.; Auw-Hädrich, C.; Meyer-ter-Vehn, T.; Emrani, E.; Reinhard, T. Fusarium keratitis with dramatic outcome. Ophthalmologe 2017, 114, 462–465. [Google Scholar] [CrossRef] [PubMed]
- Azor, M.; Gené, J.; Cano, J.; Guarro, J. Universal in vitro antifungal resistance of genetic clades of the Fusarium solani species complex. Antimicrob. Agents Chemother. 2007, 51, 1500–1503. [Google Scholar] [CrossRef] [PubMed]
- Niu, L.; Liu, X.; Ma, Z.; Yin, Y.; Sun, L.; Yang, L.; Zheng, Y. Fungal keratitis: Pathogenesis, diagnosis and prevention. Microb. Pathog. 2020, 138, 103802. [Google Scholar] [CrossRef]
- Muraosa, Y.; Oguchs, M.; Yahsro, M.; Watanabe, A.; Yaguchs, T.; Kames, K. Epidemiological study of Fusarium species causing invasive and superficial fusariosis in Japan. Med. Mycol. J. 2017, 58, E5–E13. [Google Scholar] [CrossRef] [PubMed]
- Subcommittee on Antifungal Susceptibility Testing of the ESCMID European Committee for Antimicrobial Susceptibility Testing. EUCAST Technical Note on the method for determination of broth dilution minimum inhibitory concentrations of antifungal agents for conidia-forming moulds. Clin. Microbiol. Infect. 2008, 14, 982–984. [Google Scholar] [CrossRef] [PubMed]
- Lalitha, P.; Shapiro, B.L.; Srinivasan, M.; Prajna, N.V.; Acharya, N.R.; Fothergill, A.W.; Ruiz, J.; Chidambaram, J.D.; Maxey, K.J.; Hong, K.C.; et al. Antimicrobial Susceptibility of Fusarium, Aspergillus, and Other Filamentous Fungi Isolated From Keratitis. Arch. Ophthalmol. 2007, 125, 789–793. [Google Scholar] [CrossRef] [PubMed]
- Manikandan, P.; Abdel-Hadi, A.; Randhir, Y.; Singh, B.; Revathi, R.; Anita, R.; Banawas, S.; Aziz, A.; Dukhyil, B.; Alshehri, B.; et al. Antifungal susceptibilities of Fusarium and Aspergillus isolates from corneal scrapings. BioMed Res. Int. 2019, 2019, 103802. [Google Scholar] [CrossRef]
- Homa, M.; Galgóczy, L.; Manikandan, P.; Narendran, V.; Sinka, R.; Csernetics, Á.; Vágvölgyi, C.; Kredics, L.; Papp, T. South Indian isolates of the Fusarium solani species complex from clinical and environmental samples: Identification, antifungal susceptibilities, and virulence. Front. Microbiol. 2018, 9, 1052. [Google Scholar] [CrossRef]
- Roth, M.; Daas, L.; Renner-Wilde, A.; Cvetkova-Fischer, N.; Saeger, M.; Herwig-Carl, M.; Matthaei, M.; Fekete, A.; Kakkassery, V.; Walther, G.; et al. The German keratomycosis registry: Initial results of a multicenter survey. Ophthalmologe 2019, 116, 957–966. [Google Scholar] [CrossRef] [PubMed]
- Ghosh, A.K.; Gupta, A.; Rudramurthy, S.M.; Paul, S.; Hallur, V.K.; Chakrabarti, A. Fungal Keratitis in North India: Spectrum of Agents, Risk Factors and Treatment. Mycopathologia 2016, 181, 843–850. [Google Scholar] [CrossRef]
- Xie, L.; Zhong, W.; Shi, W.; Sun, S. Spectrum of Fungal Keratitis in North China. Ophthalmology 2006, 113, 1943–1948. [Google Scholar] [CrossRef] [PubMed]
- Bugnicourt, F.; Guilliermond, A. Les Fusarium et Cylindrocarpon de L’indochine; P. Lechevalier: Paris, France, 1939. [Google Scholar]
- Laverde, S.; Moncada, L.H.; Restrepo, A.; Vera, C.L. Mycotic keratitis; 5 cases caused by unusual fungi. Sabouraudia 1973, 11, 119–123. [Google Scholar] [CrossRef] [PubMed]
- Booth, C.; Clayton, Y.; Usherwood, M. Cylindrocarpon species associated with mycotic keratitis. Proc. Plant Sci. 1985, 94, 433–436. [Google Scholar] [CrossRef]
- O’Donnell, K.; Sarver, B.A.J.; Brandt, M.; Chang, D.C.; Noble-Wang, J.; Park, B.J.; Sutton, D.A.; Benjamin, L.; Lindsley, M.; Padhye, A.; et al. Phylogenetic diversity and microsphere array-based genotyping of human pathogenic fusaria, including isolates from the multistate contact lens-associated U.S. keratitis outbreaks of 2005 and 2006. J. Clin. Microbiol. 2007, 45, 2235–2248. [Google Scholar] [CrossRef]
- Raza, S.K.; Mallet, A.I.; Howell, S.A.; Thomas, P.A. An in-vitro study of the sterol content and toxin production of Fusarium isolates from mycotic keratitis. J. Med. Microbiol. 1994, 41, 204–208. [Google Scholar] [CrossRef]
- Hof, H.; Kupfahl, C. Gliotoxin in Aspergillus fumigatus: An example that mycotoxins are potential virulence factors. Mycotoxin Res. 2009, 25, 123–131. [Google Scholar] [CrossRef] [PubMed]
- Hof, H. Mycotoxins: Pathogenicity factors or virulence factors? Mycoses 2008, 51, 93–94. [Google Scholar] [CrossRef]
- Lockwood, M.B.; Crescencio, J.C.R. Adventitious sporulation in Fusarium: The yeast that were not. IDCases 2016, 3, 5–7. [Google Scholar] [CrossRef] [PubMed][Green Version]
- Kidd, G.H.; Wolf, F.T. Dimorphism in a Pathogenic Fusarium. Mycologia 1973, 65, 1371–1375. [Google Scholar] [CrossRef] [PubMed]
- Behrens-Baumann, W.; Finis, D.; Mackenzie, C.; Roth, M.; Geerling, G. Keratomycosis–Therapy standards and new developments. Klin. Mon. Fur Augenheilkd. 2015, 232, 754–764. [Google Scholar] [CrossRef]
- Daas, L.; Viestenz, A.; Bischoff, M.; Hasenfus, A.; Seitz, B. Confocal microscopy for the diagnostics of fungal keratitis. Ophthalmologe 2016, 113, 767–771. [Google Scholar] [CrossRef]
- Daas, L.; Bischoff-Jung, M.; Viestenz, A.; Seitz, B.; Viestenz, A. Confocal microscopy as an early relapse marker after keratoplasty due to Fusarium solani keratitis. Ophthalmologe 2017, 114, 66–69. [Google Scholar] [CrossRef]
- Alfaro Rangel, R.; Szentmáry, N.; Lepper, S.; Milioti, G.; Daas, L.; Langenbucher, A.; Seitz, B. Large-diameter penetrating keratoplasties are mostly due to very severe infectious keratitis and cannot always prevent secondary enucleation. Klin. Mon. Für Augenheilkd. 2021, 6–13. [Google Scholar] [CrossRef] [PubMed]
- Al-Hatmi, A.M.S.; Meis, J.F.; de Hoog, G.S. Fusarium: Molecular Diversity and Intrinsic Drug Resistance. PLoS Pathog. 2016, 12, 1–8. [Google Scholar] [CrossRef] [PubMed]
- Espinel-Ingroff, A.; Colombo, A.L.; Cordoba, S.; Dufresne, P.J.; Fuller, J.; Ghannoum, M.; Gonzalez, G.M.; Guarro, J.; Kidd, S.E.; Meis, J.F.; et al. International evaluation of MIC distributions and epidemiological cutoff value (ECV) definitions for Fusarium species identified by molecular methods for the CLSI broth microdilution method. Antimicrob. Agents Chemother. 2016, 60, 1079–1084. [Google Scholar] [CrossRef] [PubMed]
- Hoenigl, M.; Salmanton-García, J.; Walsh, T.J.; Nucci, M.; Neoh, C.F.; Jenks, J.D.; Lackner, M.; Sprute, R.; Al-Hatmi, A.M.S.; Bassetti, M.; et al. Global guideline for the diagnosis and management of rare mould infections: An initiative of the European Confederation of Medical Mycology in cooperation with the International Society for Human and Animal Mycology and the American Society for Microbiolo. Lancet. Infect. Dis. 2021, 21, e246–e257. [Google Scholar] [CrossRef]
- Te Welscher, Y.M.; Hendrik, H.; Balagué, M.M.; Souza, C.M.; Riezman, H.; de Kruijff, B.; Breukink, E. Natamycin Blocks Fungal Growth by Binding Specifically to Ergosterol without Permeabilizing the Membrane *. J. Biol. Chem. 2008, 283, 6393–6401. [Google Scholar] [CrossRef] [PubMed]
- te Welscher, Y.M.; Jones, L.; van Leeuwen, M.R.; Dijksterhuis, J.; de Kruijff, B.; Eitzen, G.; Breukink, E. Natamycin inhibits vacuole fusion at the priming phase via a specific interaction with ergosterol. Antimicrob. Agents Chemother. 2010, 54, 2618–2625. [Google Scholar] [CrossRef]
- Cvetkova, N.; Köstler, J.; Prahs, P.; Helbig, H.; Dietrich-Ntoukas, T. Prolonged topical natamycin 5 % therapy before and after keratoplasty for Fusarium keratitis. Ophthalmologe 2016, 113, 420–424. [Google Scholar] [CrossRef]
- Awwad, S.; Mohamed Ahmed, A.H.A.; Sharma, G.; Heng, J.S.; Khaw, P.T.; Brocchini, S.; Lockwood, A. Principles of pharmacology in the eye. Br. J. Pharmacol. 2017, 174, 4205–4223. [Google Scholar] [CrossRef] [PubMed]
- Fraunfelder, F.T. Extraocular fluid dynamics: How best to apply topical ocular medication. Trans. Am. Ophthalmol. Soc. 1977, 74, 457–487. [Google Scholar]
- Behrens-Baumann, W. Anti-infective drug therapy in ophthalmology—Part 1: Bacterial infections. Klin. Mon. Fur Augenheilkd. 2004, 221, 539–545. [Google Scholar] [CrossRef] [PubMed]
- Todokoro, D.; Suzuki, T.; Tamura, T.; Makimura, K.; Yamaguchi, H.; Inagaki, K.; Akiyama, H. Efficacy of Luliconazole against broad-range filamentous fungi Including Fusarium solani species complex causing fungal keratitis. Cornea 2019, 38, 238–242. [Google Scholar] [CrossRef] [PubMed]
- Behrens-Baumann, W.J. New Antimycotics in the Pipeline—For Ophthalmology Too? Klin. Mon. Für Augenheilkd. 2021, 238, 1108–1112. [Google Scholar] [CrossRef] [PubMed]
- Prakash, G.; Sharma, N.; Goel, M.; Titiyal, J.S.; Vajpayee, R.B. Evaluation of Intrastromal Injection of Voriconazole as a Therapeutic Adjunctive for the Management of Deep Recalcitrant Fungal Keratitis. Am. J. Ophthalmol. 2008, 146, 56–59.e2. [Google Scholar] [CrossRef]
- Troke, P.; Obenga, G.; Gaujoux, T.; Goldschmidt, P.; Bienvenu, A.L.; Cornet, M.; Grenouillet, F.; Pons, D.; Ranque, S.; Sitbon, K.; et al. The efficacy of voriconazole in 24 ocular Fusarium infections. Infection 2013, 41, 15–20. [Google Scholar] [CrossRef]
- Nucci, M.; Jenks, J.; Thompson, G.R.; Hoenigl, M.; Dos Santos, M.C.; Forghieri, F.; Rico, J.C.; Bonuomo, V.; López-Soria, L.; Lass-Flörl, C.; et al. Do high MICs predict the outcome in invasive fusariosis? J. Antimicrob. Chemother. 2021, 76, 1063–1069. [Google Scholar] [CrossRef]
- Cornely, O.A.; Chemnitz, J.; Brochhagen, H.G.; Lemmer, K.; Schütt, H.; Söhngen, D.; Staib, P.; Wickenhauser, C.; Diehl, V.; Tintelnot, K. Disseminated Neocosmospora vasinfecta infection in a patient with acute nonlymphocytic leukemia. Emerg. Infect. Dis. 2001, 7, 149–152. [Google Scholar] [CrossRef]
- Behrens-Baumann, W.J.; Hofmüller, W.; Tammer, I.; Tintelnot, K. Keratomycosis due to Tintelnotia destructans refractory to common therapy treated successfully with systemic and local terbinafine in combination with polyhexamethylene biguanide. Int. Ophthalmol. 2019, 39, 1379–1385. [Google Scholar] [CrossRef]
Publisher’s Note: MDPI stays neutral with regard to jurisdictional claims in published maps and institutional affiliations. |
© 2021 by the authors. Licensee MDPI, Basel, Switzerland. This article is an open access article distributed under the terms and conditions of the Creative Commons Attribution (CC BY) license (https://creativecommons.org/licenses/by/4.0/).